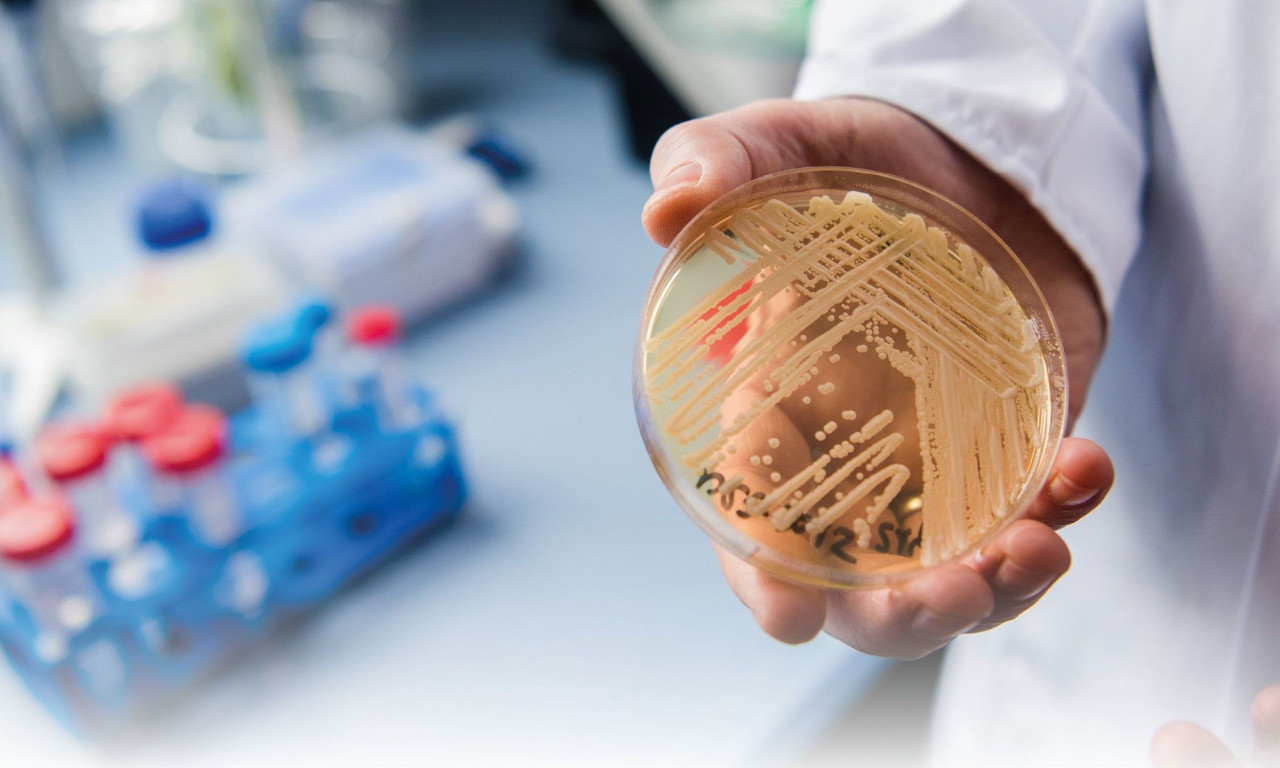

ΕΟΔΥ: Candida auris ή Candidozyma – 9 απαντήσεις για τον μύκητα που προκαλεί σοβαρές λοιμώξεις
Ο μύκητας Candidozyma auris (πρώην Candida auris) συνεχίζει να εξαπλώνεται σε όλα τα ευρωπαϊκά νοσοκομεία
Μετάβαση στην Πηγή ONMED
Author:
Πως σας φάνηκε το αρθρο?
ΑΠΙΘΑΝΟ
0
ΚΑΛΟ
0
ΜΕ ΑΡΕΣΕ
0
ΟΚ ΔΕΝ ΤΡΕΛΑΘΗΚΑ
0
ΧΑΧΑ ΕΛΑ ΠΛΑΚΑ ΚΑΝΕΙΣ
0





